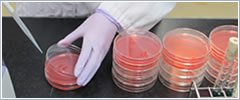

ホーム > 検査項目一覧

-

水質検査
水質検査では、事業所排水、河川水、湖沼水及び海水の水質調査や、 飲料水、プール水、浴槽水、温泉水等の検査を試料採取から分析・解析まで、一貫して自社で行っています。
食品検査
厚生労働大臣登録の食品検査機関として、食品の衛生法に基づく規格試験、食中毒菌の検査、便・尿検査等の「細菌学的検査」、食品中の残留農薬(ポジティブリスト)、栄養成分分析、異物検査といった「理化学的検査」を行います。
-
臨床検査(腸内細菌検査)
調理従事者の方を対象とした便検査
・大量調理施設衛生管理マニュアル
・学校給食衛生管理の基準
に基づく検査、また水道事業者の方を対象とした便検査も行っております。RT-PCR法(遺伝子増幅法)によるノロウィルス検査(便検査)にも対応しております。 
放射能検査
弊社では、「ゲルマニウム半導体検出器を用いたガンマ線スペクトロメトリーによる核種分析」と、「Nalシンチレーションサーベイメータを用いた測定」の放射能検査を実施しています。
土壌分析・廃棄物分析
土壌分析部門では、土壌汚染対策法に基づく調査・特定有害物質の分析をはじめ、 土壌養分分析、肥料分析、肥料分析、産業廃棄物の 溶出量試験・含有量試験等の分析を行っています。
大気測定
工場・事業所から排出される大気・悪臭の測定、有害大気等の調査や、大気汚染防止法に基づいたボイラー・焼却炉などのばい煙の測定を行っています。
ダイオキシン類分析
大気中のダイオキシン類分析をはじめ、水質、土壌、廃棄物等のダイオキシン類測定分析、調査、研究などをトータルにサポートしています。
作業環境測定・室内環境測定
作業環境測定部門では、有害物質を使用する作業場内での空気環境測定や分析評価を、室内環境測定部門では、学校や住宅のシックハウス調査(ホルムアルデヒドやトルエンなどの調査分析)や、建物の解体時のアスベストの調査、建材中のアスベスト分析等を行っています。
騒音・振動測定
騒音・振動規制法に基づく測定や環境調査、自動車騒音の面的評価、周波数分析等の各種調査から 解析、対策の立案までをご提案いたします。
自然環境調査・生物の同定分析
河川水辺の国勢調査や建設事業のモニタリング調査、生物の分類・同定など、様々な自然環境調査業務を行っています。

























